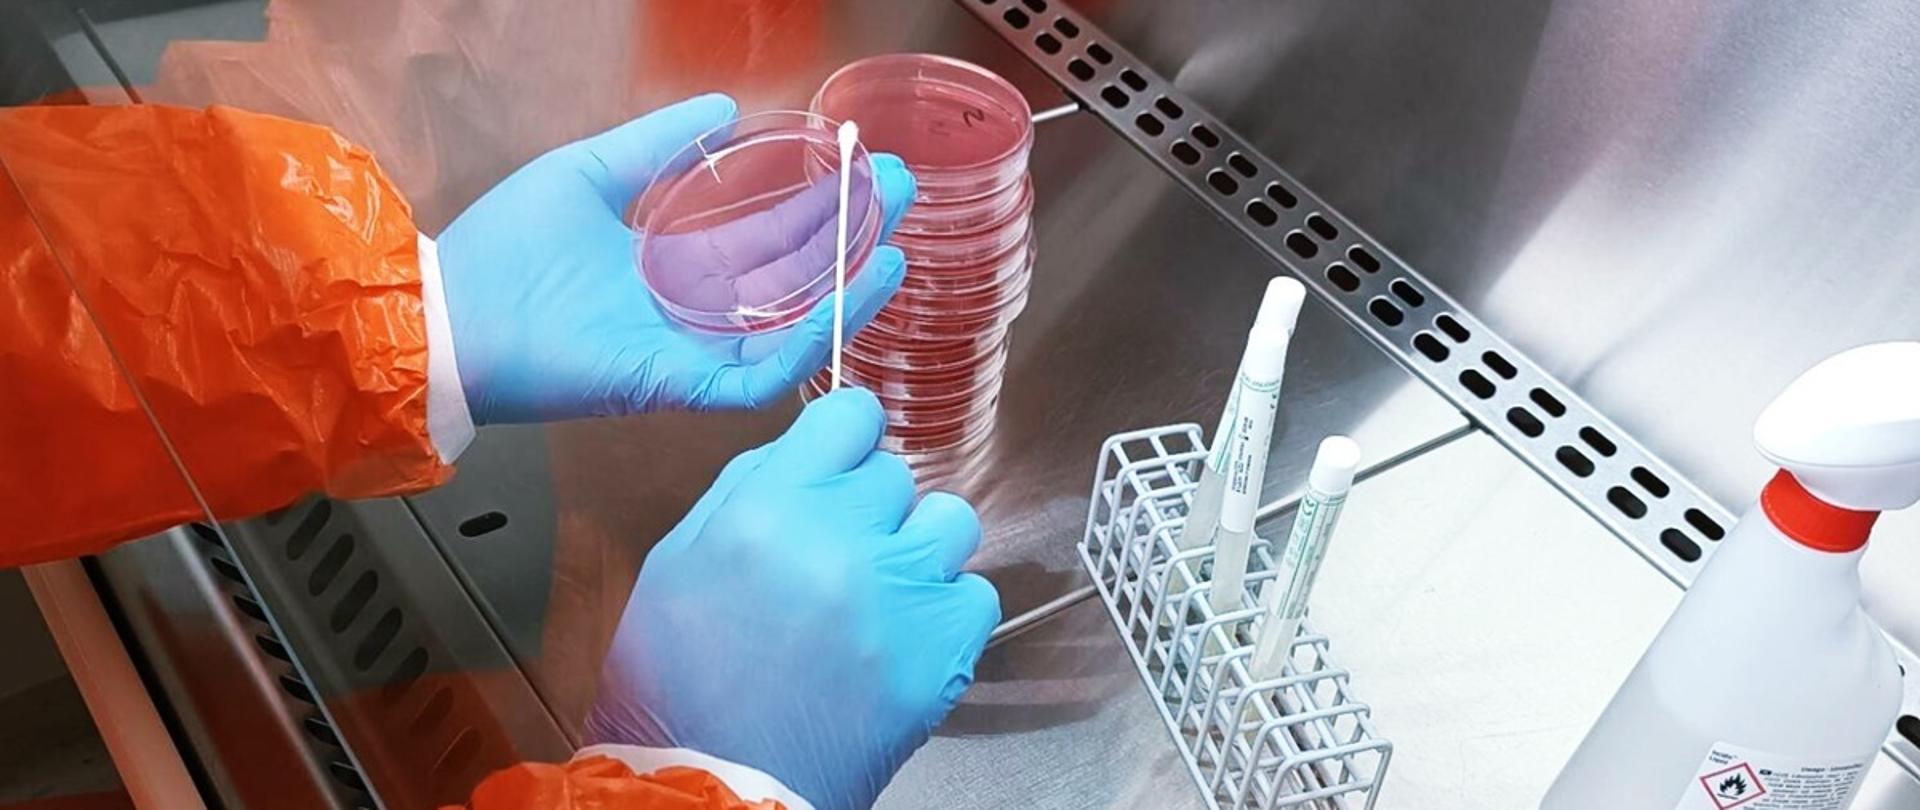
Laboratorium

Laboratorium PSSE w Puławach
-
30.10.2025Na podstawie Rozporządzenia Ministra Zdrowia z dnia 23 października 2025 r. w sprawie wykazu stacji sanitarno-epidemiologicznych wykonujących badania laboratoryjne i pomiary (data ogłoszenia 29.10.2025 r.) Oddział Laboratoryjny PSSE w Puławach, ul. Kilińskiego 22, z dniem 1 stycznia 2026 r. zaprzestaje wykonywania badań laboratoryjnych.
-
Poniżej znajdą Państwo wzory wniosków o udostępnienie z Archiwum PSSE w Puławach kopii wyników badań w kierunku diagnostyki zakaźnych chorób jelitowych (Salmonella / Shigella)